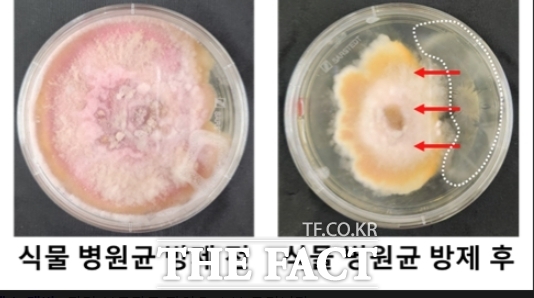
식물 병원균의 노출 상태(왼쪽)와 치료균 캡슐 투입 후 병원균 제거 상태(오른쪽)/인하대학교

[더팩트ㅣ인천=김재경 기자] 인하대학교는 양윤정 생명공학과 교수 연구팀이 최근 멍게 껍질로 친환경적 생물농약 캡슐을 개발했다고 14일 밝혔다.
연구팀은 사람이 먹지 않는 멍게 껍질의 셀룰로오스를 활용해 토양 내에서 분해되는 생물농약 전달 캡슐을 만들었다.
병해충에 감염된 식물들이 주로 알칼리성 토양에서 생존한다는 점과 비가 내린 뒤 병원균의 확산이 급격하게 이뤄진다는 점을 주목, 이를 통해 토양 내 pH(수소 이온 농도 지수) 변화와 수분에 따른 반응으로 내용물이 방출되도록 자가 반응형 캡슐을 설계했다.
연구팀이 개발한 캡슐은 식물의 병원균을 억제하는 치료균을 내장하고 있으며, 알칼리성 환경에서 수분을 만나 파열·방출돼 병든 식물의 뿌리와 주변 토양에 작용해 병해충을 효과적으로 제어하는 원리를 가진다.
이러한 소재의 생산 공정은 이상현 건국대 교수 연구팀이 개발한 바 있다.
양윤정 인하대 생명공학과 교수는 "이번 연구는 해양 부산물을 고부가가치 생물농약 소재로 전환한 사례로, 친환경 소재개발과 순환경제 실현에 기여할 수 있을 것"이라고 말했다.
한편 이번 연구는 해양수산과학기술진흥원의 해양수산부산물 바이오 소재화 기술개발사업과 연구재단의 지원을 받아 수행했으며, 연구팀의 이번 성과가 담긴 논문은 바이오 분야의 권위있는 학술지인 ‘Biomacromolecules’ 최신호에 게재됐다.
infact@tf.co.kr